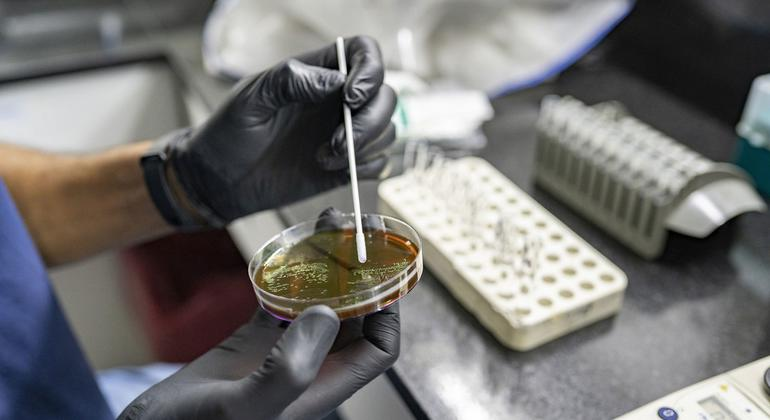

La Organización Mundial de la Salud (OMS) ha declarado la resistencia antimicrobiana (RAM) como una emergencia sanitaria global, ante el acelerado aumento de infecciones que ya no responden a los tratamientos disponibles. La advertencia refuerza años de llamados a una acción urgente, en un contexto donde el desarrollo de nuevos antibióticos no avanza al mismo ritmo que la resistencia de las bacterias.
La resistencia antimicrobiana ocurre cuando bacterias, virus u otros microorganismos evolucionan y dejan de responder a los medicamentos diseñados para eliminarlos. Esto hace que infecciones comunes, como neumonías o infecciones urinarias, se vuelvan más difíciles de tratar e incluso mortales.
Un impacto global creciente
El problema ya tiene un alto costo en vidas humanas. Un estudio publicado en The Lancet estimó que en 2019 la RAM bacteriana fue responsable directa de 1.27 millones de muertes en el mundo y estuvo relacionada con casi 5 millones de fallecimientos.
Datos más recientes señalan que en 2021 se registraron 1.14 millones de muertes directamente atribuibles, y las proyecciones advierten que esta cifra podría aumentar a 1.91 millones anuales para 2050 si no se toman medidas efectivas.
Además, un informe de la OMS reveló que en 2023 una de cada seis infecciones bacterianas confirmadas fue resistente a antibióticos. La situación es más crítica en regiones como Asia Sudoriental y el Mediterráneo Oriental, donde hasta una de cada tres infecciones presenta resistencia.
Uno de los casos más preocupantes es el aumento de bacterias resistentes a carbapenémicos, antibióticos considerados de “último recurso”. Su pérdida de eficacia reduce significativamente las opciones de tratamiento, especialmente en países con menos recursos.

Avances médicos en riesgo
El director general de la OMS, Tedros Adhanom Ghebreyesus, advirtió que la resistencia antimicrobiana está superando los avances de la medicina moderna. Esto pone en riesgo procedimientos médicos que dependen de antibióticos eficaces, como cirugías, tratamientos contra el cáncer o trasplantes.
Sin medicamentos efectivos, infecciones que antes eran tratables pueden convertirse en amenazas graves, aumentando hospitalizaciones, costos médicos y mortalidad.
Respuesta internacional en marcha
Ante este escenario, la comunidad internacional ha comenzado a coordinar acciones. En 2024, la Asamblea General de las Naciones Unidas acordó reducir en un 10% las muertes asociadas a la RAM para 2030.
La OMS, por su parte, impulsa un nuevo Plan de Acción Mundial para el período 2026–2036, enfocado en mejorar el uso de antibióticos, fortalecer la vigilancia y promover la investigación.
También se han sumado iniciativas desde el sector privado y académico. Más de 50 organizaciones firmaron el Pacto de Davos sobre la RAM, mientras que en Estados Unidos se presentó la Ley SUPER BUGS para impulsar la investigación. Además, científicos han desarrollado nuevas herramientas basadas en tecnología CRISPR que podrían ayudar a eliminar la resistencia en bacterias.
Falta de nuevos tratamientos

Uno de los principales desafíos es la escasez de nuevos antibióticos. Actualmente, solo siete proyectos innovadores se encuentran en fases avanzadas de desarrollo a nivel mundial para combatir los patógenos más peligrosos.
La OMS ha señalado la urgencia de invertir en investigación y desarrollo, ya que sin nuevos tratamientos, muchas infecciones podrían volverse intratables en el futuro.
Una carrera contra el tiempo
Expertos coinciden en que la lucha contra la resistencia antimicrobiana requiere acciones coordinadas: uso responsable de antibióticos, mayor inversión en ciencia y políticas de salud pública más estrictas.
La próxima Conferencia Ministerial de Alto Nivel sobre la RAM, prevista en junio en Nigeria, será clave para evaluar avances y definir nuevas estrategias.
Mientras tanto, la advertencia es clara: sin medidas inmediatas, la resistencia antimicrobiana podría convertirse en una de las principales amenazas para la salud global en las próximas décadas.

Más historias
Súper Selectos lanza campaña nacional de reciclaje electrónico durante junio
Holcim alcanza 40% de energía térmica con aprovechamiento sostenible de residuos
Vecinos de Nejapa tienen agua potable segura gracias a nueva infraestructura hídrica